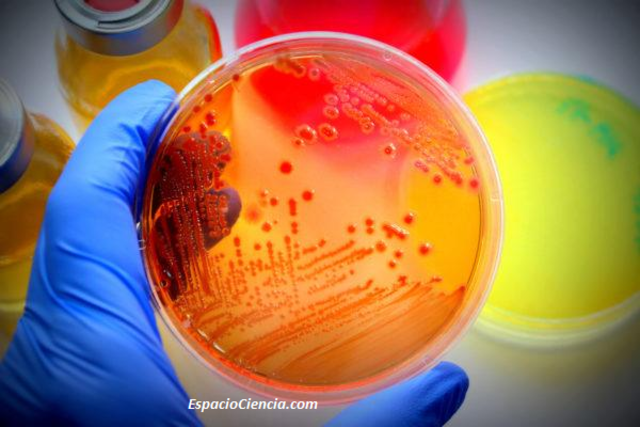
Los aspectos microbiológicos en el proceso cobran importancia

-
El registro mas antiguo que la humanidad tiene de este proceso data al año 2000 A.C., nuestros ancestros hervían el agua en el fuego o con la ayuda del sol para eliminar las impurezas y los sedimentos que esta contenía.
-
El tratado de aguas industriales comenzó en el siglo XIX gracias a la Revolución Industrial. Se relata que el descubrimiento de este proceso fue gracias a un accidente en el cual se olvidaron papas dentro de la caldera y una vez que se dieron cuenta del error los trabajadores pudieron ver que la limpieza de la misma era mucho más fácil.
-
Dichas patentes comenzaron utilizando compuestos orgánicos como los taninos, compuestos fenólicos que se encuentran en algunas plantas y años mas tarde se empezaron a utilizar otro tipo de compuestos como el Di-Sodio de Fosfato y el Tri-Sodio de Fosfato, aunque dichos compuestos fueron muy útiles y prácticos resultaron muy problemáticos ya que ocasionaban inestabilidad en las calderas.
-
Los tratamientos de agua en las torres de enfriamiento empezaron a desarrollarse cada vez mas, dichos procesos comenzaron con un ajuste en el pH de estos tratamientos.
-
Este indice fue utilizado para determinar las tendencias corrosivas o incrustantes en del agua para uso doméstico e industrial.
-
En esta década se introdujeron catalizadores de una naturaleza diferente como el sulfato de sodio para remover con una rapidez mucho mayor el oxigeno, ademas compuestos como, el nitrato de sodio fueron utilizados para disminuir la formación de corrosión en las calderas.
-
Se realizaron diversas investigaciones de estos compuestos ya que eran muy útiles para controlar la corrosión que el dióxido de carbono provocaba, dichos estudios se realizaron en las líneas de condensación.
-
Dicho indice fue utilizado al igual que el indice de Langelier para determinar la estabilidad de agua utilizada para enfriamiento y para proporcionar una mejor indicación en la tendencia a la formación de incrustaciones de carbonato de calcio.
-
Este combustible fue utilizado para eliminar el oxigeno en calderas que soportaban presiones muy altas, años después se comprobó que dicho compuesto tenia una toxicidad y peligrosidad muy alta.
-
Estos agentes fueron utilizados mayormente para eliminar la toxicidad de los metales pesados en el agua tratada, lamentablemente no fueron utilizados bajo las condiciones correctas lo que ocasiono desviaciones en el comportamiento de estos compuestos.
-
Se propuso el uso de estos compuestos como agentes que inhibían la corrosión y a partir de diversos estudios en los cuales cambiaban las condiciones bajo las cuales estaban, como el pH y la transferencia de calor se dedujo que eran eficaces.
-
A medida que el tiempo avanzaba los estudios en los efectos de la actividad microbiológica también, se evaluaron como este aspecto actuaba frente a la corrosión de las calderas. También se realizaron estudios de los efectos del sulfato sobre la reducción de las bacterias.
-
La industria de esa época estaba mas interesada en reducir costos y aumentar ganancias que en las repercusiones que sus acciones tenían en el ambiente, el cual poco a poco fue ganando mayor importancia.
-
El impacto sobre el medio ambiente y la salud humana fue tomando cada vez mas relevancia, lo que provocó la prohibición del uso de sustancias como, el cromato y el acido sulfurico.
-
Este compuesto cobro popularidad ya que tenia los mismos efectos de los compuestos como el cromato y el ácido sulfúrico pero no tenia efectos tan negativos como los mismos y ademas tenia una gran facilidad para probarse bajo distintas condiciones
-
El proceso de tratamiento de aguas se fue volviendo cada vez más lucrativo y fue así como distintas compañías se formaron, entre ellas hubo seis que sobresalieron, como: Nalco, Betz, Calgon, Dearbonr, Drew and Mogul las cuales dominaron el mercado estadounidense de la época.
-
Por sus siglas en ingles la AWT (Association of Water Technologies) es una asociación independiente formada por varias compañías que tienen el mismo giro industrial de suma importancia incluso actualmente ya que hasta el día de hoy ofrece servicios como eventos educacionales y asistencia en numerosos sectores.
-
Se hicieron diversas transacciones entre las compañías más importantes de la época en las cuales las empresas más grandes compraron a las empresas que estaban sobresaliendo cada vez más, como por ejemplo Mogul que fue comprada por Nalco y años más tarde Betz compro a Dearborn.
-
Sin duda Estados Unidos se convirtió en una potencia a nivel mundial en este sector gracias a todas las compañías nacionales, una de las más importantes fue U.S. Filters la cual se convirtió en el mayor proveedor de equipos en el mercado.
-
Con el pasar de los años se generó una gran preocupación por el medio ambiente gracias a esto se crearon mejores procesos y más accesibles como la osmosis inversa, la utilización de membranas y la microfiltración.
-
Este elemento químico que había tenido un gran auge años atrás se encontraba bajo ataque ya que a pesar de que no tenía efectos tan negativos como los compuestos usados anteriormente también tenía un impacto sobre el medio ambiente y se crearon nuevas regulaciones para controlar el uso del molibdeno y en que cantidades podía ser usado.
-
Francia al igual que Estados Unidos también ha sido una potencia en este sector, pero fue a finales de 1990 que empezó a ganar cada vez más territorio, como, por ejemplo, Suez Lyonnaise des Eaux Group compro las compañías más importantes de la época, Nalco y Calgo Corporation.
-
Hércules era una compañía que fusionó dos de las compañías más renombradas a nivel mundial, después de que GE adquirió cambio su nombre a GE Water Technogies. Después la compañía compró a Glegg y Osmonics y así se fue consolidando como una de las empresas más completas en el sector.
-
Se añadieron nuevos compuestos como polímeros dispersantes de alto rendimiento que soportaban condiciones como presiones muy elevadas. Esto permitió aumentar la eficiencia del proceso y disminuir el desperdicio del agua utilizada.
-
Las membranas fueron cobrando cada vez más importancia ya que minimizaban considerablemente los costos de energía y mejoraba los procesos de purificación de agua y de tratamiento de aguas residuales.
Looking for a timeline maker?
Create timelines for projects, roadmaps, history, lessons, legal cases, and stories with Timetoast. Timetoast is a timeline maker for work, school, research, and stories.